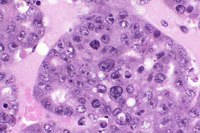
Dual Transgenic Mouse Liver

The Digitized Atlas of Mouse Liver Lesions

Much of the work carried out by DTT is in support of the National Toxicology Program (NTP), an interagency partnership of the Food and Drug Administration, National Institute for Occupational Safety and Health, and NIEHS.
Visit the NTP Website(The last 12 Images from Chapter 21 of Pathology of Genetically Engineered Mice (2000). JM Ward, JF Mahler, RR Maronpot, JP Sundberg, Eds. with permission of Iowa State University Press, Ames, Iowa)
Ductular formation of hepatocytes in this 2-week old AL-TAg x AL-myc mouse has a predominantly centrilobular localization.
An altered hepatocyte focus is arising in an area of ductular formation in this 2-week old AL-TAg x AL-myc mouse.
Focal areas of bile duct proliferation also arise within areas of ductular formation in 2-week old AL-TAg x AL-myc mice.
Increased severity of focal bile duct proliferation associated with an area of ductular formation in a 3-week old AL-TAg x AL-myc mouse.
Areas of ductular formation and bile duct proliferation can be extensive in the livers of 3-week old AL-TAg x AL-myc mice.
By 4-weeks of age much of the liver is replaced by areas of ductular formation, cholangial neoplasms, and hepatocellular neoplasms in AL-TAg x AL-myc mice.
Higher magnification of liver lesions in a 4-week old AL-TAg x AL-myc mouse.
Higher magnification of a well differentiated cholangiocarcinoma in a 4-week old AL-TAg x AL-myc mouse.
A hepatocellular carcinoma in a 4-week old AL-TAg x AL-myc mouse.
Hepatocytomegaly, karyomegaly, and a mitotic figure in a 39- day-old transgenic mouse.
Bromodeoxyuridine immunohistochemistry from a normal liver showing a low labeling index and from a 39-day-old mouse with a high labeling index.
Basophilic focus in liver of a 4-week-old transgenic mouse.
Multiple biliary and hepatocellular hyperplastic and neoplastic lesions in the liver of a 4-week-old transgenic mouse.
Confluent biliary and hepatocellular neoplasms totally occupying the left liver lobe of a 4-week-old transgenic mouse.
Hepatocellular adenoma and bile duct carcinoma in a 4-week-old transgenic mouse.
A proliferative cystic biliary lesion, a solid basophilic adenoma, and a bile duct adenoma in a 4-week-old transgenic mouse.
Juxtaposition of a bile duct adenocarcinoma and a hepatocellular adenoma in a 4-week-old transgenic mouse.
Anaplastic cytology is present in this hepatocellular carcinoma in a transgenic mouse.
Cholangiocarcinoma next to a more adenomatous lesion with hepatocyte cytological features in a 4-week-old transgenic mouse.